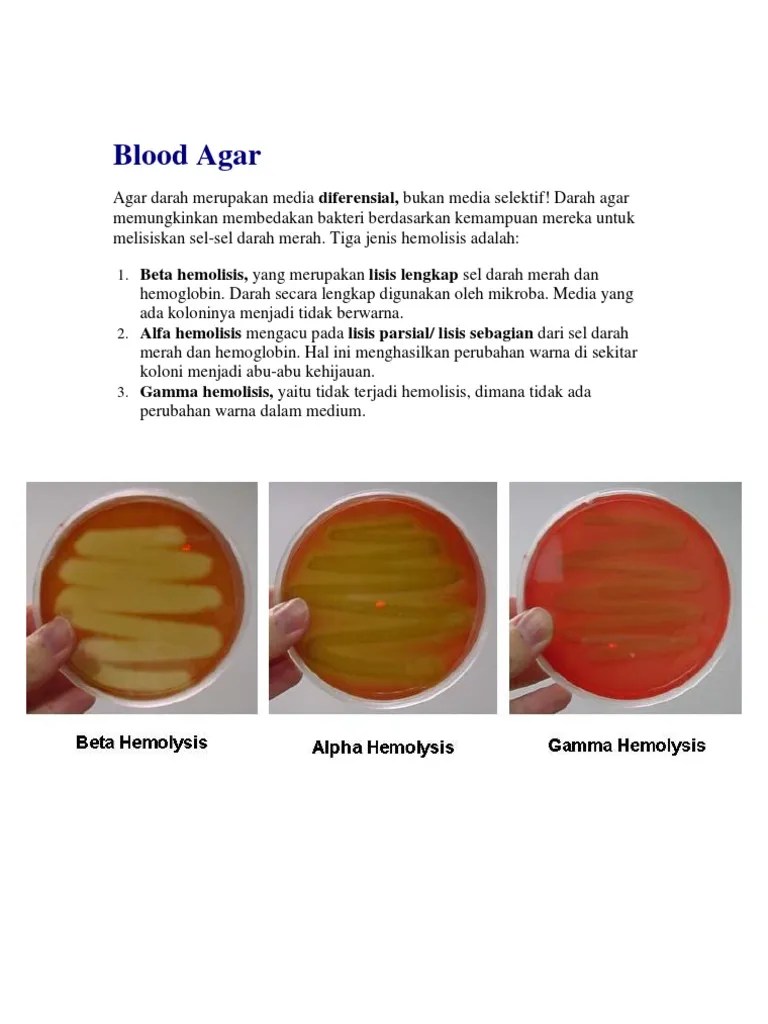
Blood Agar | PDF

Jual Media agar darah II Blood Agar Base ready to use II 10 Plate - Jakarta Pusat - DEOLABORA | Tokopedia

Jual Blood Agar Base/Agar Darah/Media Blood Agar/Media Agar Darah - Kab. Bantul - nitrakimia | Tokopedia

Medical Laboratory Technologist: Media Blood Agar Plate (BAP)

Jual Blood Agar Base atau Agar Darah 100 gram Merck di Lapak Ophin Alat Lab Alkes | Bukalapak
Jual 6 BAP / 6 benzylaminopurin Indonesia|Shopee Indonesia

Jual Glucose Agar, 500 Gram - Kota Bogor - Toko Alat dan Bahan Lab | Tokopedia
Bap & Uji Hemolisis | PDF
Media Bap Kelompok 4 | PDF

Blog Analis Mikrobiologi: Blood Agar Plate Dan Uji Hemolisi
Jual Alkohol cap Betet kadar 70% isi 100 ml Indonesia|Shopee Indonesia

Blood Agar - Definisi, Komposisi, Cara Pembuatan dan Interpretasi Hasil - MicrobeHolic

Foto Stok Bacteria Culture Blood Culture Colony Bacteria (Edit Sekarang) 1034115775

SINDOgrafis: GeNose Jadi Modal Indonesia Hadapi Pandemi Covid-19

BKIPM Bandung MASAGI on Twitter: “BAP - Blood Agar Plate mrpkn media pertumbuhan bakteri yg membedakan bktri pathogen berdasarkan efek exotoksin hemolitik bktri pd eritrosit https://t.co/bzmraswbq8" / Twitter
Jual Hormon BAP 30 ml Bud Breaker Penumbuh Bunga Anggrek Indonesia|Shopee Indonesia

Kuasa hukum Nurhadi tak keberatan Hengky ubah keterangan dalam BAP - ANTARA News

Jual Bap di Jawa Timur - Harga Terbaru 2022

Nasi Quinoa Pengganti Nasi Agar Lebih Sehat - Nasi Sehat Kongbap

Terima Duit Jual-Beli Jabatan, Bupati Cirebon Buka Rekening Atas Nama ODGJ
Agar Darah (BAP) | PDF
Bakteri Dalam Media Budaya Foto Stok - Unduh Gambar Sekarang - iStock
Blood Agar | PDF

Jual Kongbap Multi Grain Mix Chiaseed & Quinoa di Lapak House of Organix | Bukalapak

Jual Vla Vanila Untuk Isian Kue | Tokowahab.com

Patroli PPKM Berskala Mikro Terus Berlanjut, Petugas Pemko Medan Berikan BAP Kepada Restoran dan Cafe
Toko “Cahaya Matahari” - Cepuk Bulat (Kecil-Sedang-Besar) | Facebook

Tim Patroli Prokes Beraksi, Dua Pemilik Usaha Di-BAP-kan
![Jual Kongbap Chiaseed & Quinoa Multi Grain Mix - Kuning [25 g/6 pcs] - 6 Pack di Seller Kesehatan Vegan - Kota Jakarta Barat, DKI Jakarta | Blibli](https://i0.wp.com/www.static-src.com/wcsstore/Indraprastha/images/catalog/full//1063/kongbap_kongbap-chiaseed---quinoa-multi-grain-mix--25-g-6-pcs-_full02.jpg)
Jual Kongbap Chiaseed & Quinoa Multi Grain Mix - Kuning [25 g/6 pcs] - 6 Pack di Seller Kesehatan Vegan - Kota Jakarta Barat, DKI Jakarta | Blibli
Isolasi dan Identifikasi Streptococcus spp

Stok Darah Menipis, Ayo Bantu PMI Batam - kabarsiger.com

BAP Tersangka Ayah Cabul Anak Kandung di Kupang Tengah Dinyatakan Lengkap - Pos-kupang.com

Jual Obat Cialis Asli Di Semarang 085340319671 Harga Promo by Koeng Chun - issuu

Jual Kacang Almond Slice 1Kg di Lapak TOKO ASBA7 | Bukalapak

Diet Karbo Nasi Kongbap, Cara Sehat Menurunkan Berat Badan - Nasi Sehat Kongbap

AKAD DALAM HUKUM ISLAM

obat gula darah tinggi: Jual BASMUT, Pembasmi Semut Modern

Mengenal 5 Manfaat Sayur Kol, Salah Satunya Menurunkan Kolesterol Halaman all - Kompas.com
![Jual KONGBAP Chiaseed & Quinoa Multi Grain Mix [1 kg] di Seller Dede collection - Kota Jakarta Barat, DKI Jakarta | Blibli](https://i2.wp.com/www.static-src.com/wcsstore/Indraprastha/images/catalog/full//90/MTA-2169071/kongbap_kongbap-chiaseed---quinoa-multi-grain-mix-1-kg_full02.jpg)
Jual KONGBAP Chiaseed & Quinoa Multi Grain Mix [1 kg] di Seller Dede collection - Kota Jakarta Barat, DKI Jakarta | Blibli

Hakim Minta JPU Beri Salinan BAP ke Korban Kejahatan Perbankan di BJB Pekanbaru - Cakaplah - Berpikir Berbuat Bercakap

10 Alasan Kuat Mengapa Harus Khawatir Terhadap Resistensi Antibiotik

Diperiksa 10 Jam, Eks Kepala UPT Pasar Probolinggo Ubah 20 Poin BAP | Radar Bromo

Kesal Sepeda Motor Sering Dikembalikan Rusak, Pria di Tapanuli Bakar Teman Sendiri

Pelumas Silicon Treadmill Ori Lubricate Oil | Lazada Indonesia

Puluhan Santri di Pesantren Al-Manar Terima Vaksin | Berita Aceh Poe

Apa fob BAP? -definisi BAP | Singkatan Finder

Klinik Aborsi di Jakarta Pusat Bagikan Untung 50 Persen ke Calo, Pasien Tanpa Calo Harga Lebih Mahal - Tribunnewswiki.com Mobile
Agar Darah | PDF

Naufal Samudra Sudah 2 Kali Beli Liquid Ganja
Pemanfaatan darah manusia yang kadaluarsa sebagai pengganti darah domba dalam pembuatan media Agar Darah Plat (ADP) The use of e

Penyidik Polri Dikonfirmasi soal BAP Prasetijo yang Dicabut Halaman all - Kompas.com

MIKROBIOLOGI UNTUK TEHNISI KESEHATAN: BAP

Tidak Patuhi Surat Edaran Wali Kota, Petugas Tegur dan BAP Pelaku Usaha

Pemuda Harapan Bangsa di Grobogan Gunakan Bansos Prakerja Untuk Beli Seribu Pil Koplo

BAP DPD RI Mediasi Pengaduan Penghuni Rumah Negara Eks PNS PJKA Bandung | Page 2 - JPNN.com Mobile
Antibiogram Menunjukkan Sensibilitas Bakteri Streptococcus Pada Hidangan Petri Foto Stok - Unduh Gambar Sekarang - iStock

Trixolshop Terbukti Ampuh Obat Herbal Mariza Tetes Mata Minus Plus Luka Kotor Berair Bernanah - Bukalapak.com | inkuiri.com

Jaksa KPK Buka Bukti Chat Azis Syamsuddin dengan Walkot Tanjungbalai

Keterangan Zaenal Tayeb di BAP dan Sidang Beda, Hakim Perintahkan Jaksa Panggil Penyidik Kepolisian - Tribun-bali.com

Kongbap Nasi Sehat Kaya Serat - Nasi Sehat Kongbap

Vicky Prasetyo Jalani BAP Atas Laporan untuk Adik Angel Lelga, Kasus Apa?

PMI Kota Tangerang Rinci Harga Darah, Biaya Donor Rp 146.414 Dipertanyakan

Terjawab Nih, Harga Darah Mahal Padahal Donor Darah Gratis, Ini Alasannya - Tribunjabar.id

KPPU: Aqua dan distributor terbukti bersalah

Jual Permen Soloco Asli Di Cikarang 085340319671 Tahan Lama by Koeng Chun - issuu

Jual Obat Mata Juling Walatra Sehat Mata Softgel Asli - Obat Mata Minus - Rabun - Kanker - Tumor - Silinder - Glaukoma Terbaru Desember 2021 harga murah - kualitas terjamin - Blibli

KAJIAN MEDIA TANAM DAN KONSENTRASI BAP (Benzyl Amino Purin) TERHADAP PERTUMBUHAN SETEK TANAMAN BUAH NAGA DAGING PUTIH

Viral Soal Darah ‘Dijual’ Mahal, PMI Tegaskan Tidak Ada Mafia Darah
PEMANFAATAN DARAH SISA TRANSFUSI DALAM PEMBUATAN MEDIA BAP UNTUK PERTUMBUHAN BAKTERI Streptococcus pyogenes

7 Rekomendasi Jam Tangan Wanita Garmin Terbaik - Doran Gadget

Maria Lumowa dituntut 20 tahun penjara - ANTARA News

5 cairan paling mahal sedunia: 1. Darah | kumparan.com

Jual Obat Darah Tinggi, Penurun Darah Tinggi, Obat Hipertensi,

DETEKSI Staphylococcus aureus PENYEBAB MASTITIS SUBKLINIS PADA KERBAU PERAH (Bubalus bubalis) DI KABUPATEN ENREKANG SKRIPSI OLEH WAHYUNI O - PDF Download Gratis

Suap Jual Beli Jabatan di Kemenag, Romahurmuziy Dituntut 4 Tahun Penjara